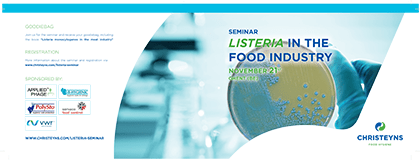
Listeria Event Programme

Seminarie : Listeria in the Food Industry – 21 november, 2019
Listeria monocytogenes is een bacterie die de infectieziekte Listeriose veroorzaakt. De bacterie wordt vaak aangetroffen in rauwe voedingsproducten zoals melk, vlees, gevogelte, vis, rauwe groenten en fruit. Listeria heeft het vermogen om te overleven tijdens koeling en zelfs bij temperaturen van 1 ° C. Onnodig te zeggen dat deze bacterie een belangrijk risico kan vormen voor de volksgezondheid. Afgezien van de mogelijk ernstige gezondheidsproblemen, kunnen uitbraken leiden tot product recalls, productiestilstanden en een zwaar beschadigde merkreputatie.
Christeyns Food Hygiene organiseert een wetenschappelijk seminarie over dit belangrijke voedselveiligheidsprobleem. Gastsprekers van onder andere Campden BRI, Universiteit Gent en ILVO schetsen de problemen rond Listeria en bieden mogelijke oplossingen voor optimale preventie en controle.
Programma (presentaties in het Engels)
Voor wie?
Dit seminarie is bedoeld voor alle werknemers in de voedingsindustrie die verantwoordelijk zijn voor voedselveiligheid en kwaliteit (kwaliteitsmanagers, productiemanagers, …)
Waar & wanneer
We verwelkomen u graag op ons seminarie in Gent (België) op 21 november, van 9h00 tot +/- 15h30
Locatie : Communicatiecampus – Auditorium4 Sint-Denijslaan 485 9000 Gent
Een lekkere lunch is inbegrepen in het programma. Natuurlijk 100% Listeria-vrij.
Reservaties
Wegens grote interesse is het niet langer mogelijk om in te schrijven voor dit evenement. Alle plaatsen zijn volzet.
Heeft u toch nog vragen of wenst u meer informatie, gelieve dan contact op te nemen.